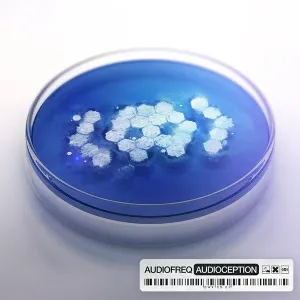
Pochette de Audioception de Audiofreq

Écoute gratuite de Audioception
Rechercher sur Amazon
Partager
Crédits
Artiste principal
Première parution
Edition présentée
- Région : Belgique
- Label : Dirty Workz
- Pistes : 21
- Durée : 77min 33sec
- Support : 1 CD
- Code-barres : 5425007456004
- Langue principale : Anglais
Genres musicaux
Playlist
21 titres Durée 77:33
- 1Audioception Part 1 (Prologue) 1:34
- 2Audioception Part 2 (Exposition) 4:47
- 3Escape 3:49
- 4Desire 4:43
- 5Screwdriver 4:03
- 6Chase 4:52
- 7Drumz 4:04
- 8The Gospel 3:37
- 9Speekaz Kikk 5:04
- 10Ghyl (Intermission) 1:44
- 11Mutate 6:11
- 12Volition 4:17
- 13Time Machine 4:17
- 14Outlaw 3:56
- 15Brnfnk 2:47
- 16Russian Sleep Experiment 3:55
- 17Caged 3:32
- 18Trigger 4:05
- 19Prelude To The Future (Intermission) 0:57
- 20Welcome To The Future 4:22
- 21Public Service Announcement (Epilogue) 0:57